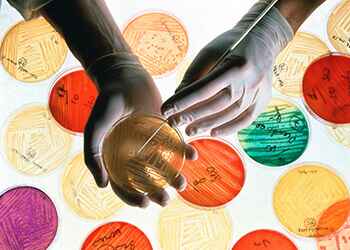
Лечение ЗППП у женщин

- Главная
- |
- Лечение урогенитальных инфекций
Лечение ЗППП (заболевания передающиеся половым путем)


Их около 20 названий, начиная от безоговорочного лидера в этой сфере - трихомониаза, и заканчивая крайне редко встречающимся в нашей стране мягким шанкром или исключительно африканским вирусом Зика. И все это - заболевания, которые можно приобрести исключительно во время интимной близости. Ну а лечение ЗППП в зависимости от причины может приносить либо полное выздоровление, либо продолжительную ремиссию. Или, к примеру, адекватная терапия, погашая активность вирусов герпеса, отправляет их "спать", раз уж пока не найдено эффективного лекарства.
Львиную долю в классификации урогенитальных инфекций занимают, конечно же, бактерии (названные древними греками "палочками") и вирусы (переводимые с латыни, как "яд" даже не клетки, а просто частицы). Чаще всего, результатом внедрения и размножения первых становятся хламидиоз, гонорея, сифилис, уреаплазмоз. Вирусы становятся причиной нескольких видов герпеса (крайне опасных в период вынашивания плода), папилломы человека (способных спровоцировать развитие онкологической патологии), ВИЧ и множества видов гепатита.
Лечение заболеваний передающихся половым путем
Объяснять необходимость проведения полноценной терапии в данном случае не нужно. Достаточно помнить о том, что на первый взгляд безобидная инфекция может лишить вас возможности стать родителями или осложниться фатально опасной патологией.
Регулярные профилактические осмотры, полноценная точная диагностика и своевременное лечение ЗППП у женщин позволят избежать хронических воспалений, неизменно ведущих к бесплодию или лишающих возможности выносить ребенка. В некоторых случаях (к примеру, цитомегаловирус) без адекватной терапии во время беременности велик шанс тяжелых врожденных патологий у малыша.
Опять же вовремя проведенное лечение ЗППП у мужчин обезопасит от таких тяжелых осложнений, как простатит - главный виновник бесплодия и импотенции.
Важно помнить о пагубном влиянии хламидий на сердце, органы зрения и слуха, суставы, дыхательную систему, сосуды. При этом заболевание часто принимает затяжной хронический характер практически незаметно для больного, и в этом смысле только ваша собственная забота о своем здоровье, а именно - регулярные профилактические осмотры, - позволит избежать осложнений.
Нередко лечение урогенитальных инфекций требует особого индивидуального подхода, поскольку протекают они сочетанно, и каждая нуждается в специальном лечении. Только опытный врач, основываясь на результатах точной диагностики может сформировать оптимальные схемы лечения в подобных случаях.
На самом деле, в диагностике, скажем так, интимных болезней существует множество нюансов и эти мероприятия, как и лечение ЗППП в СПб лучше доверять специализированным клиникам.
Центр гепатологии и вирусных инфекций располагает всеми необходимыми ресурсами для точной диагностики, и при необходимости вы можете пройти полноценное лечение ЗППП в Приморском районе, где располагается наш Центр.
Прием ведут
Цены на услуги по лечению ЗППП (заболеваний передающиеся половым путем)
| № | Наименование | Стоимость |
|---|---|---|
| 1 |
Прием специалиста |
от 2700 до 5900 |
| № | Наименование | Стоимость |
|---|---|---|
| 1 |
Прием специалиста |
от 2300 до 4000 |